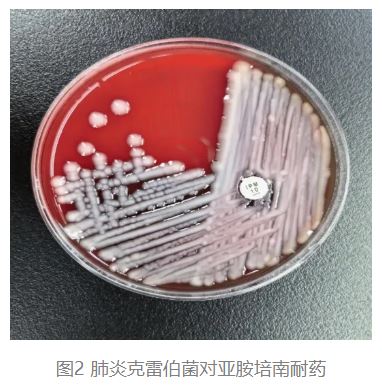
1773966368278180.jpg
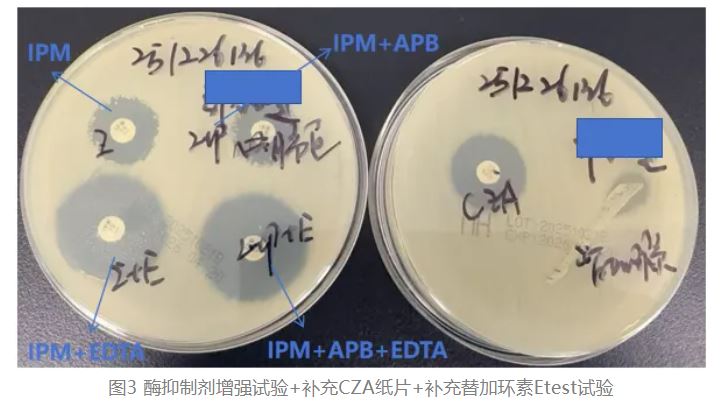
1773966376259851.jpg
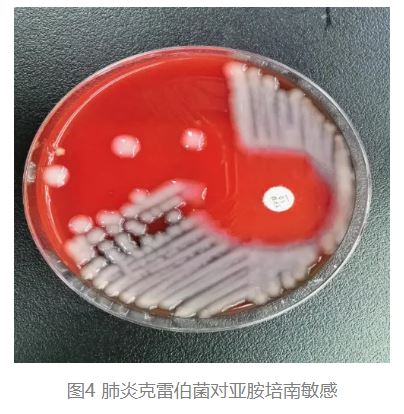
1773966410150626.jpg

亚胺培南纸片初筛的CRKP药敏检测流程优化与实践
作者:何天娇,辛娜,王青 ,姚子淳等,西安医学院第一附属医院
,姚子淳等,西安医学院第一附属医院
前言:CRKP流行现状与实验室检测新挑战
肺炎 克雷伯菌(Klebsiella pneumoniae,KP) 是克雷伯氏菌属中最为重要的一种细菌,也是引发医院感染的常见条件致病菌,相关数据显示,近年来,KP在中国地区的临床分离率始终稳居第二位[1]。
克雷伯菌(Klebsiella pneumoniae,KP) 是克雷伯氏菌属中最为重要的一种细菌,也是引发医院感染的常见条件致病菌,相关数据显示,近年来,KP在中国地区的临床分离率始终稳居第二位[1]。
随着侵入性操作的日益增多、碳青霉烯类抗菌药物 的广泛使用、免疫抑制药物的普遍应用等因素的影响,CRKP感染在全球范围内呈现出不断上升的趋势; 同时,多项研究表明,CRKP感染有着较高的死亡率,增加了住院时间及医疗资源的消耗,目前已经成为全球公共卫生的重大威胁[2]。CRKP检出率的逐年上升,不仅给临床抗感染治疗带来巨大挑战,也对实验室微生物检测的精准性与时效性提出了更高要求。作为检验科微生物室的一员,在日常工作中,对于肺炎克雷伯菌培养不纯需分纯,而如何在分纯过程中优化药敏检测流程、提升CRKP筛查效率、合理利用检测资源,成为我们持续探索的核心问题。经过长期实践与总结,一套以亚胺培南(IPM)纸片初筛为核心的检测策略,让我们在实践中收获了诸多深刻感悟。
现存困境:肺炎克雷伯菌分纯及药敏检测的痛点分析
微生物检测的核心价值在于为临床提供及时、准确的药敏结果,而CRKP作为 “超级细菌” 之一,其早期筛查与精准鉴定直接关系到患者治疗方案的制定与医院感染的防控。在以往的工作中,对于不纯培养物分纯后的肺炎克雷伯菌,我们常直接采用统一板卡进行药敏检测,往往存在 “过度检测” 或 “检测滞后” 的问题:若菌株对高阶抗生素(粘菌素、替加环素、头孢他啶/阿维巴坦 )敏感,使用含多种高阶抗生素的板卡会造成资源浪费,且检测流程较长(需要补充药敏);若菌株为CRKP,低阶抗生素板卡则无法满足临床需求,需重新检测,延误报告发放时间,见图1。
)敏感,使用含多种高阶抗生素的板卡会造成资源浪费,且检测流程较长(需要补充药敏);若菌株为CRKP,低阶抗生素板卡则无法满足临床需求,需重新检测,延误报告发放时间,见图1。

这种 “一刀切” 的模式,既难以适配临床对精准诊疗的需求,也不符合实验室高效运转的原则。
优化策略:亚胺培南纸片初筛分流检测方案的建立与实施
基于这一痛点,我们针对肺炎克雷伯菌,优化了分纯流程:在平板原始区直接贴IPM纸片,经 18-24 小时左右培养后观察抑菌圈。若出现耐药表型,说明菌株大概率为CRKP,见图2。
此时直接选择 N355等含高阶抗生素较多的板卡进行检测,同时结合药敏仪器可能存在的检测偏差,补充替加环素、头孢他啶/阿维巴坦(CZA)及酶型检测,确保耐药基因与表型结果的一致性,见图3;
若IPM敏感,见图4,则选用 N334、GNO9等含低阶抗生素的板卡,无需进行多余的高阶抗生素检测。这一 “初筛分流” 策略,让我们在实践中切实感受到了 “精准” 带来的改变。
实践成效:初筛分流策略在效率、成本与准确性上的提升
首先,检测效率显著提升。对于亚胺培南敏感的菌株,通过低阶抗生素板卡检测,避免了不必要的检测步骤,平均缩短发报告时间12-18小时,为临床早期选用合适的低阶抗生素提供了及时依据,尤其对于轻症感染患者,快速的药敏结果能有效减少治疗延误,提升治疗效果。
其次,资源利用更加合理。高阶抗生素检测板卡成本相对较高,通过亚胺培南初筛,将敏感菌株与耐药菌株分流,避免了将高阶板卡用于无需检测的敏感菌株,显著降低了检测成本,同时减少了酶型检测、肉汤法、Etest法等补充检测的盲目使用,让有限的实验室资源集中用于真正需要精准鉴定的CRKP菌株,实现了 “好钢用在刀刃上”。
更重要的是,检测准确性得到保障。药敏仪器虽能实现高通量检测,但在部分特殊耐药表型(如异质性耐药)的检测中可能存在偏差,而IPM纸片初筛能直观反映菌株的耐药表型,结合替加环素肉汤法或者Etest法的手工补充检测与酶型检测,形成了 “表型 + 手工验证” 的双重保障,有效避免了漏检或误判。在实践中,我们通过这一流程成功检出多例仪器初筛未明确的CRKP 菌株,为医院感染防控提供了关键数据,有效降低了 CRKP在院内传播的风险。
实践感悟与未来展望:精准检测助力耐药菌防控
这一实践过程也让我们深刻认识到,实验室检测并非简单的 “按流程操作”,而是需要结合临床需求与菌株特点,不断优化流程、创新方法。肺炎克雷伯菌CRKP的检出率上升,本质上是耐药菌与抗菌药物博弈的结果,而实验室作为耐药菌监测与防控的 “前哨”,不仅要能准确检出耐药菌,更要通过高效、精准的检测,为临床合理用药提供支持,从源头减少耐药菌的产生与传播。亚胺培南初筛分流策略的成功应用,正是实验室主动适应临床需求、践行 “精准医疗” 理念的体现。
未来,我们还将持续关注耐药菌的流行趋势与检测技术的发展,进一步优化初筛指标与分流标准,探索更快速、更灵敏的CRKP 筛查方法,同时加强与临床的沟通协作,将实验室检测结果与临床治疗效果相结合,形成 “检测 - 治疗 - 反馈 - 优化” 的闭环,为提升医院抗感染治疗水平与耐药菌防控能力贡献更大力量。在对抗耐药菌的道路上,实验室的每一次流程优化、每一个精准结果,都是守护患者健康的重要防线,而这份 “精准施策、高效防控” 的实践感悟,也将激励我们不断精进技术、砥砺前行。
【参考文献】
[1]郭燕 ,胡付品
,胡付品 ,朱德妹,等.2022 年 CHINET 三级医院细菌耐药 监测[J].中国感染与化疗杂志,2024,24( 3) :277-286.
,朱德妹,等.2022 年 CHINET 三级医院细菌耐药 监测[J].中国感染与化疗杂志,2024,24( 3) :277-286.
[2]王忠杰,阙蜜,袁喆,等.呼吸重症监护室患者感染耐碳青霉烯类 肺炎克雷伯菌和死亡危险因素分析[J].西南医科大学学报, 2024,47( 2) : 147-151.
来源:检验医学网
